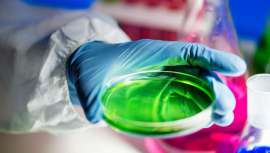

-
Un posible nuevo ritual de belleza
-
Innovación, conocimiento y negocio se dan cita en Nutraceuticals Europe 2026
Nutraceuticals Europe 2026 reunirá en Ifema Madrid a la industria internacional de ingredientes funcionales en dos jornadas dedicadas a la innovación, el conocimiento y el negocio
-
Glosario Cosmetología Actual
Un práctico repaso a los términos que definen la cosmetología actual
-
La nueva ley de aparatología avanzada en los centros de estética
Muchas son las dudas todavía por parte de profesionales, alumnos y empresas fabricantes y distribuidoras de la estética acerca de la nueva ley de la UE que entrara en vigor en 2021. Resumimos y contestamos a tus preguntas en el siguiente artículo
-
CONCURSO BEAUTY MARKET ESTÉTICA
Beauty Market y mesoestetic® regalan 6 packs de productos mesoprotech®, protección solar de amplio espectro y máxima eficacia
Tecnologías avanzadas y nuevos formatos que facilitan la aplicación y maximizan la eficacia de sus productos
Se han obtenido 401 artículos en TOTAL. Mostrando del 361 al 401